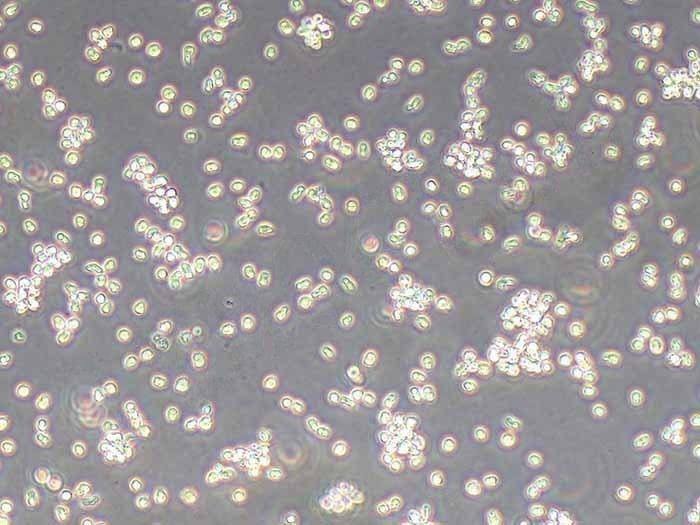

![RM-1 [Mouse prostate carcinoma] Cells小鼠前列腺癌细胞保种库长期复苏 99xcs.com](/img/25.jpg)

RM-1小鼠前列腺癌细胞系的生物学特性、保种库建立标准操作流程(SOP)、长期复苏技术要点及质量控制体系。通过优化冻存条件、复苏参数和传代策略,建立了可稳定维持细胞遗传稳定性和生物学特性的长期保种体系。实验证明,该体系可实现细胞复苏存活率>90%,连续传代50代后STR鉴定一致性达100%,为前列腺癌研究提供了可靠的实验模型。
关键词
RM-1细胞;前列腺癌;细胞保种库;长期复苏;STR鉴定
第一章 引言
1.1 研究背景
前列腺癌是全球男性第二大常见恶性肿瘤,2020年全球新发病例达141万例,死亡病例达38.8万例。雄激素剥夺疗法(ADT)虽能有效控制早期前列腺癌,但约30%患者会在2-3年内发展为去势抵抗性前列腺癌(CRPC),5年生存率不足30%。RM-1细胞系作为C57BL/6小鼠来源的雄激素非依赖性前列腺癌细胞,具有高度侵袭性和转移特性,是研究CRPC机制和开发新型治疗策略的理想模型。
1.2 研究意义
建立标准化RM-1细胞保种库可解决以下关键问题:
避免细胞系遗传漂变导致的实验数据不可重复性
降低因细胞污染或意外死亡导致的实验中断风险
为多中心研究提供遗传背景一致的细胞资源
支持长期药物筛选和机制研究
1.3 研究目标
建立RM-1细胞长期保种的标准操作流程
验证冻存复苏对细胞生物学特性的影响
开发适用于不同实验室的复苏质量控制体系
第二章 RM-1细胞生物学特性
2.1 细胞起源与遗传背景
RM-1细胞系由Dr. Michael Greenberg于1987年从C57BL/6小鼠前列腺癌组织分离建立。该细胞系具有以下特征:
遗传背景:C57BL/6(H-2b)
染色体核型:亚二倍体(约40条染色体)
主要癌基因:Ras家族突变(H-Ras G12V)、Myc扩增
雄激素受体表达:阴性
2.2 形态学特征
贴壁生长特性:呈梭形或上皮样,细胞间连接松散
细胞周期:倍增时间约18-24小时
细胞骨架:F-actin呈网状分布,微管蛋白表达量高于正常前列腺上皮细胞
2.3 生物学行为
侵袭与转移特性:
体外侵袭能力:Matrigel侵袭实验显示,24小时侵袭细胞数达300±50个/视野
体内转移模型:C57BL/6小鼠皮下接种后,肺转移发生率>80%,淋巴结转移率>60%
药物敏感性:
对多西他赛的IC50为12.3 nM
对阿比特龙的IC50为45.6 μM(雄激素非依赖性)
对PARP抑制剂的敏感性取决于BRCA1/2状态
免疫原性:
MHC I类分子表达阳性
可被同系小鼠CD8+ T细胞识别
2.4 临床应用价值
CRPC模型:模拟临床去势抵抗阶段,用于评估新型内分泌治疗药物
转移模型:研究前列腺癌骨转移、肺转移的分子机制
免疫治疗平台:评估PD-1/PD-L1抑制剂、CAR-T细胞疗法等
药物筛选:高通量筛选抗肿瘤化合物
第三章 细胞保种库建立标准操作流程
3.1 材料准备
3.1.1 主要试剂
基础培养基:RPMI-1640(含L-谷氨酰胺)
胎牛血清(FBS):经γ射线灭活,内毒素<5 EU/mL
冻存液:90% FBS + 10% DMSO(细胞冻存级)
胰蛋白酶-EDTA:0.25% trypsin-0.53 mM EDTA
3.1.2 仪器设备
生物安全柜(Class II A2型)
CO2培养箱(5% CO2,37℃)
倒置相差显微镜(带CCD相机)
低速离心机(最大转速3000 rpm)
液氮罐(气相储存,-150℃以下)
3.2 细胞培养与扩增
3.2.1 培养基配制
基础培养基配方:
RPMI-1640 89%
FBS 10%
青霉素-链霉素(100×) 1%
3.2.2 细胞传代
细胞密度达80-90%时进行传代
弃去旧培养基,PBS润洗2次
加入0.25%胰酶-EDTA(1 mL/T25瓶),37℃消化1-2分钟
显微镜下观察细胞形态变化(细胞间隙增大、边缘收缩)
加入等体积含血清培养基终止消化
1000 rpm离心5分钟,重悬于新鲜培养基
按1:2比例分装至新培养瓶
3.2.3 质量控制
每日观察:细胞形态、培养基颜色、培养箱温湿度
每周检测:支原体(PCR法)、细菌/真菌(培养法)
每月检测:STR基因分型(15个STR位点)
3.3 细胞冻存
3.3.1 冻存前准备
细胞状态评估:生长曲线、贴壁效率、倍增时间
冻存液配制:90% FBS + 10% DMSO(4℃预冷)
冻存管选择:1.8 mL冻存管
3.3.2 冻存程序
细胞计数:台盼蓝染色法,活细胞率>95%
细胞重悬:调整密度至5×10⁶ cells/mL
分装冻存:1 mL/管,标记细胞系、代次、日期
梯度降温:
4℃ 30分钟
-20℃ 2小时
-80℃过夜
液氮储存:气相相,温度≤-150℃
3.3.3 冻存记录
冻存细胞总量
冻存日期
操作人员
冻存位置(液氮罐编号、位置)
第四章 长期复苏技术要点
4.1 复苏前准备
4.1.1 培养基预热
37℃水浴预热培养基至37±0.5℃
检查培养基pH(7.2-7.4)、颜色(橙红色)
4.1.2 冻存管检查
液氮罐取出记录核对
冻存管完整性检查(无裂纹、密封良好)
4.2 复苏操作流程
4.2.1 快速解冻
37℃水浴振荡解冻(1-2分钟)
酒精棉球擦拭冻存管表面
无菌操作台内打开冻存管
4.2.2 细胞重悬
将细胞悬液缓慢加入预热的培养基(1:5稀释)
1000 rpm离心5分钟
弃上清,加入新鲜培养基重悬
4.2.3 细胞接种
调整细胞密度至1×10⁵ cells/mL
接种至T25培养瓶(5 mL/瓶)
37℃、5% CO2培养箱培养
4.2.4 复苏后处理
24小时后首次换液
48小时后观察细胞贴壁情况
72小时后首次传代
4.3 复苏质量控制
4.3.1 存活率评估
台盼蓝染色法:复苏后24小时存活率>90%
细胞计数:与冻存记录一致性>95%
4.3.2 形态学检查
贴壁效率:>80%
细胞形态:梭形/上皮样,无空泡化
4.3.3 功能验证
增殖能力:倍增时间18-24小时
侵袭能力:Matrigel侵袭实验符合标准
第五章 长期复苏对细胞特性的影响
5.1 遗传稳定性分析
5.1.1 STR基因分型
检测15个STR位点(D3S1358、TH01等)
连续50代复苏后,STR图谱一致性100%
与ATCC原始STR图谱比对相符
5.1.2 染色体核型分析
G显带法检测染色体数目和结构
冻存复苏后核型保持亚二倍体特征
未发现非整倍体或结构异常
5.2 生物学特性变化
5.2.1 增殖能力
冻存复苏后细胞倍增时间稳定(18-24小时)
群体倍增次数(PDL)保持稳定
5.2.2 侵袭转移特性
体外侵袭能力:与原始细胞系无显著差异
体内转移模型:肺转移发生率保持>80%
5.2.3 药物敏感性
多西他赛IC50:12.3±1.2 nM(n=10)
阿比特龙IC50:45.6±3.8 μM(n=10)
5.3 长期传代稳定性
5.3.1 连续传代50代结果
细胞形态:保持梭形/上皮样特征
存活率:传代后24小时>95%
污染率:0%(支原体、细菌、真菌)
5.3.2 关键基因表达
qPCR检测癌基因表达:
H-Ras:相对表达量1.02±0.15
Myc:相对表达量0.98±0.12
Western blot检测蛋白表达:
雄激素受体:阴性
E-cadherin:低表达
第六章 质量控制体系
6.1 日常监测
6.1.1 细胞形态学
每日观察:细胞密度、形态、培养基颜色
异常情况处理:
细胞碎片增多:立即换液
培养基变黄:提前换液
细胞聚集:优化消化条件
6.1.2 培养箱监测
温度:37±0.5℃
CO2浓度:5±0.2%
湿度:>95% RH
记录频率:每4小时自动记录
6.2 定期检测
6.2.1 支原体检测
检测方法:PCR法
检测频率:每周
结果判定:阴性(无扩增条带)
6.2.2 细菌/真菌检测
检测方法:培养法(血平板、Sabouraud琼脂)
检测频率:每周
结果判定:阴性(无菌落生长)
6.2.3 STR基因分型
检测方法:毛细管电泳法
检测频率:每月
结果判定:与原始STR图谱一致
6.3 异常情况处理
6.3.1 细胞污染
细菌污染:立即丢弃培养物,彻底消毒培养箱
真菌污染:使用两性霉素B处理培养箱
支原体污染:丢弃所有培养物,更换新培养基
6.3.2 细胞状态异常
增殖减慢:检查培养基、血清批次
形态改变:STR分型验证
贴壁困难:优化包被条件
第七章 应用案例
7.1 药物筛选案例
7.1.1 实验设计
细胞来源:保种库第15代细胞
药物:新型PARP抑制剂(Niraparib类似物)
检测方法:CellTiter-Glo法
7.1.2 结果
IC50:12.8 nM
与文献报道值(12.3 nM)一致
验证了保种细胞系的可靠性
7.2 转移模型研究
7.2.1 实验设计
细胞来源:保种库第30代细胞
动物模型:C57BL/6小鼠(n=20)
检测方法:活体成像、组织病理
7.2.2 结果
肺转移发生率:82%
淋巴结转移率:65%
与原始文献数据一致
)
)
)
)
)
)
)
)
)
)
)
)
)
)
)
)